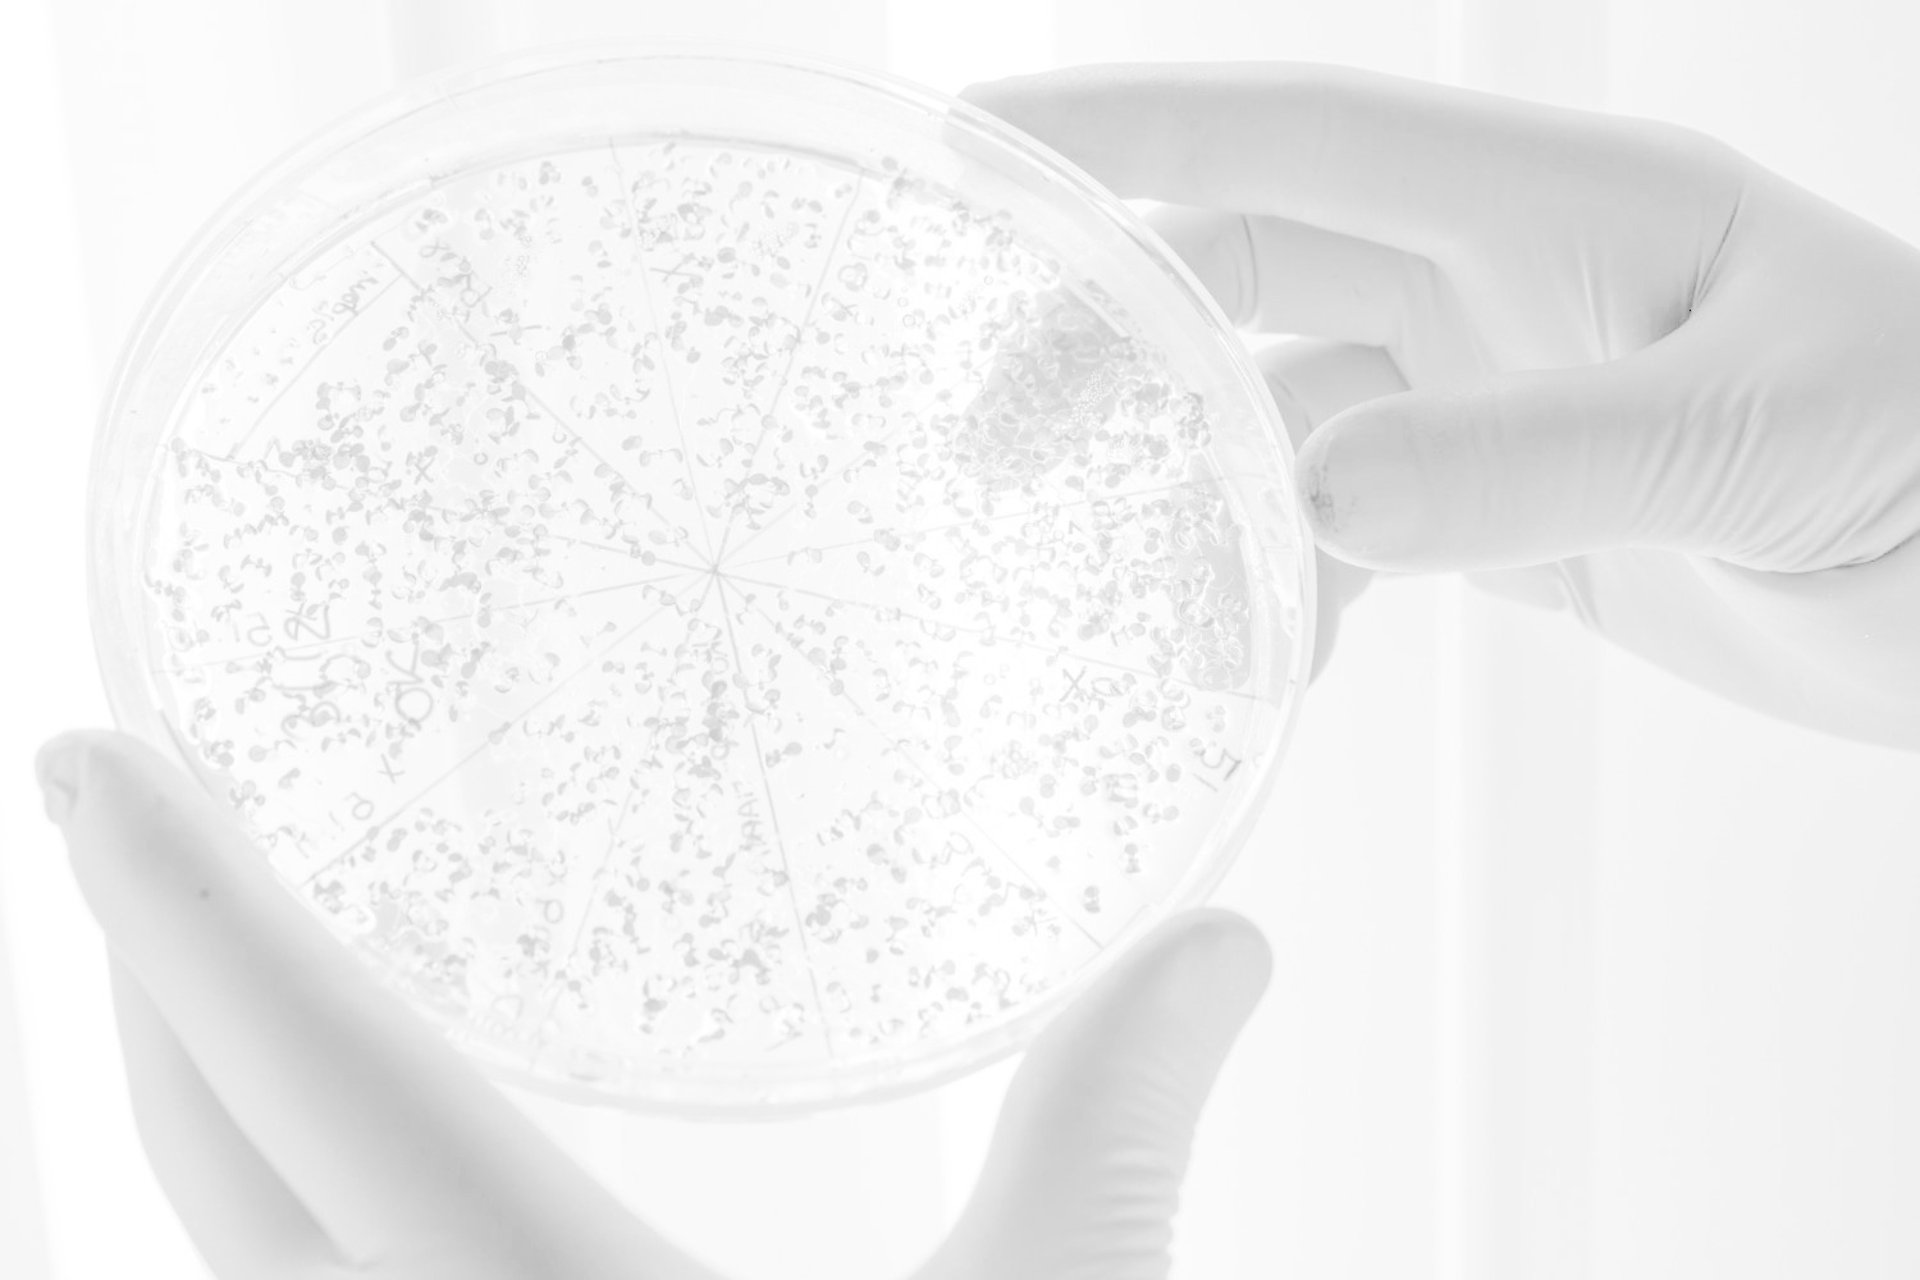

Microbiología

Discos de Antibiograma
Los sensidiscos para diagnóstico in vitro permite determinar la susceptibilidad bacteriana mediante el método de difusión en agar estandarizado por el CLSI. Disponibles en presentaciones de 50 unidades, en frasco o dispensador, estos discos de celulosa impregnados garantizan precisión y repetibilidad en la medición de halos de inhibición. Su fabricación bajo estrictos controles con cepas ATCC asegura resultados confiables para la orientación de tratamientos antibióticos en el laboratorio clínico.




Emarin SDA S.A.

Discos de Antibiograma
Los sensidiscos para diagnóstico in vitro permite determinar la susceptibilidad bacteriana mediante el método de difusión en agar estandarizado por el CLSI. Disponibles en presentaciones de 50 unidades, en frasco o dispensador, estos discos de celulosa impregnados garantizan precisión y repetibilidad en la medición de halos de inhibición. Su fabricación bajo estrictos controles con cepas ATCC asegura resultados confiables para la orientación de tratamientos antibióticos en el laboratorio clínico.




Emarin SDA S.A.

Los medios de cultivo deshidratados de Micromedica están formulados bajo estrictos estándares internacionales para garantizar el aislamiento primario y la caracterización de microorganismos en muestras clínicas, farmacéuticas y ambientales. Compuestos por nutrientes de alta pureza como infusiones de carne y aminoácidos, estos agares proporcionan una base nutricional óptima que asegura un crecimiento bacteriano lujurioso y resultados altamente reproducibles. Gracias a su excelente capacidad de gelificación y estabilidad de pH, representan la solución ideal para laboratorios que requieren estandarización en pruebas de susceptibilidad antimicrobiana y control de calidad microbiológico




Medios de Cultivo
Contamos con gran variedad de items para distintos usos.

Los medios de cultivo deshidratados de Micromedica están formulados bajo estrictos estándares internacionales para garantizar el aislamiento primario y la caracterización de microorganismos en muestras clínicas, farmacéuticas y ambientales. Compuestos por nutrientes de alta pureza como infusiones de carne y aminoácidos, estos agares proporcionan una base nutricional óptima que asegura un crecimiento bacteriano lujurioso y resultados altamente reproducibles. Gracias a su excelente capacidad de gelificación y estabilidad de pH, representan la solución ideal para laboratorios que requieren estandarización en pruebas de susceptibilidad antimicrobiana y control de calidad microbiológico




Medios de Cultivo
Contamos con gran variedad de items para distintos usos.

Los medios de cultivo deshidratados poseen una gran variedad de aplicaciones, tanto en microbiología industrial (industria alimentaria, cosmética, farmacéuticas, producción de vacunas, salud animal, laboratorios de análisis, etc.) como en laboratorios de microbiología clínica. La presentación en forma de polvo deshidratado confiere al medio de cultivo una mayor vida útil de hasta 5 años, permitiendo prepararlos de manera cómoda y sencilla. La alta calidad de las materias primas utilizadas en su producción, así como los estrictos controles de calidad realizados durante todo el proceso, hacen que los medios de cultivo deshidratados de Condalab sean la mejor opción para su laboratorio garantizando una máxima recuperación y rendimiento.


Medios de Cultivo Deshitratados



Los medios de cultivo deshidratados poseen una gran variedad de aplicaciones, tanto en microbiología industrial (industria alimentaria, cosmética, farmacéuticas, producción de vacunas, salud animal, laboratorios de análisis, etc.) como en laboratorios de microbiología clínica. La presentación en forma de polvo deshidratado confiere al medio de cultivo una mayor vida útil de hasta 5 años, permitiendo prepararlos de manera cómoda y sencilla. La alta calidad de las materias primas utilizadas en su producción, así como los estrictos controles de calidad realizados durante todo el proceso, hacen que los medios de cultivo deshidratados de Condalab sean la mejor opción para su laboratorio garantizando una máxima recuperación y rendimiento.


Medios de Cultivo Deshitratados




